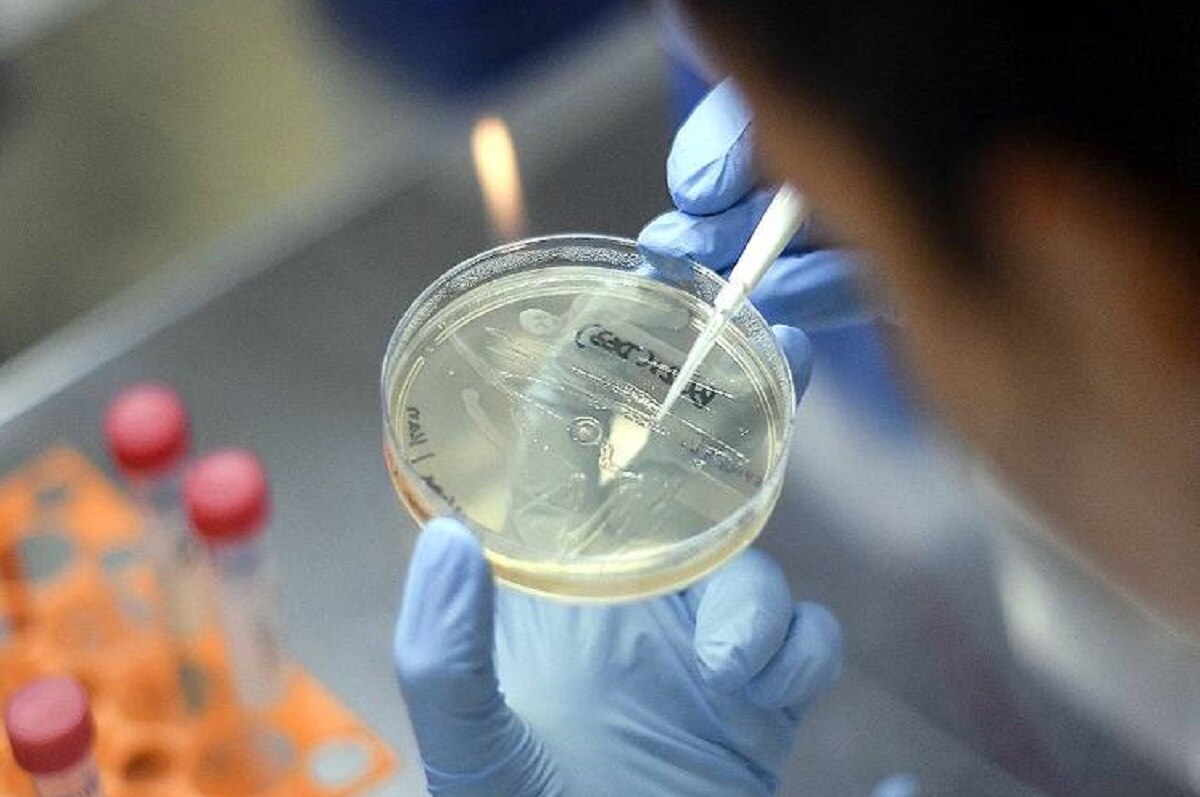
टमाटर में पार्किंसंस रोग का इलाज

ब्रिटिश वैज्ञानिकों ने टमाटर में ढूंढा पार्किंसंस रोग का इलाज!
वैज्ञानिकों ने खतरनाक पार्किंसंस रोग के लिए टमाटर में एक ऐसे तत्व की खोज की है जिससे इस रोग से लड़ने में सहायता प्राप्त हो सकती है. यह तत्व टमाटर की जीएम क्रॉप की मदद से तैयार किया गया है. (Photos: File)
साइंस डेली की एक रिपोर्ट के मुताबिक, पार्किंसन रोग की दवा के लिए प्रयुक्त एल-डीओपीए खास स्रोत है. इसके प्राकृतिक स्रोत के रूप में टमाटर के जीएम पौधे का उपयोग उन लोगों के लिए लाभप्रद होगा जो पार्किंसंस के प्रभाव से ग्रसित हैं.
ब्रिटेन स्थित जॉन इनस सेंटर के एक डॉक्टर के नेतृत्व वाली टीम ने इसके बारे में शोध किया है. टीम के मुताबिक एल-डीओपीए के संश्लेषण के लिए जिम्मेदार एक जीन के जरिए टमाटर फल को संशोधित किया गया. इसके बाद कई चरण की प्रक्रिया समाप्त करने के बाद इस निष्कर्ष पर पहुंचा गया.
हालांकि रिपोर्ट के मुताबिक, अभी इस शोध और इसके परिणाम को एक पाइपलाइन में लाना जरूरी है. इस शोध से संबंधित प्रोफेसर कैथी मार्टिन का कहना है कि पार्किंसंस रोग विकासशील देशों में एक बढ़ती हुई समस्या है जहां बहुत से लोग एल-डीओपीए की दैनिक कीमत का वहन नहीं कर सकते.
क्या है पार्किंसंस रोग:
पार्किंसंस रोग के शुरुआती लक्षण धीमे और कठोर होते हैं. पार्किंसन रोग एक तरह का मानसिक रोग है. इसमें व्यक्ति को चलने में परेशानी होना, शरीर में कंपन, कठोरता, तालमेल और संतुलन आदि की समस्याएं होती हैं. इसकी शुरुआत उंगली, हाथ जैसे शरीर के छोटे अंगों से भी होती है और फिर ये पूरे शरीर में फैल जाती है.